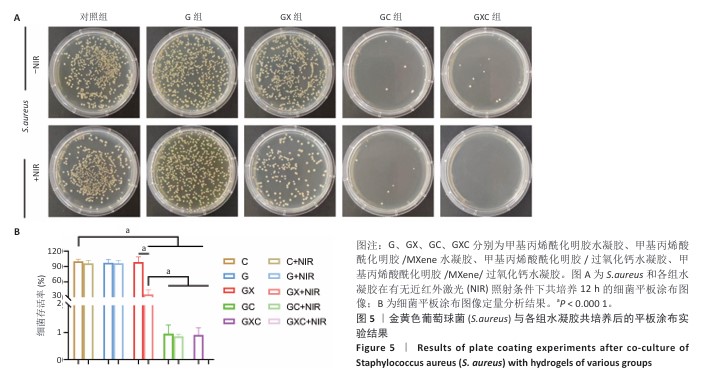

[1] TU L, FAN Y, DENG Y, et al. Production and Anti-Inflammatory Performance of PVA Hydrogels Loaded with Curcumin Encapsulated in Octenyl Succinic Anhydride Modified Schizophyllan as Wound Dressings. Molecules. 2023;28(3):1321.
[2] WANG F, ZHANG W, LI H, et al. How Effective are Nano-Based Dressings in Diabetic Wound Healing? A Comprehensive Review of Literature. Int J Nanomed. 2022;17:2097-2119.
[3] GUPTA M, NAIK AK, SINGH SK. Bacteriological profile and antimicrobial resistance patterns of burn wound infections in a tertiary care hospital. Heliyon. 2019;5(12):e02956.
[4] SUN Y, WANG J, LI D, et al. The Recent Progress of the Cellulose-Based Antibacterial Hydrogel. Gels. 2024;10(2):109.
[5] SARKHOSH-INANLOU R, SHAFIEI-IRANNEJAD V, AZIZI S, et al. Applications of scaffold-based advanced materials in biomedical sensing. Trends Anal Chem. 2021;143:116342.
[6] KANG H, HAN J, JIN M, et al. Decellularized squid mantle scaffolds as tissue-engineered corneal stroma for promoting corneal regeneration. Bioeng Transl Med. 2023;8(4):e10531.
[7] LIN J, SHI T, WANG Y, et al. Hybrid Hydrogel Loaded with Chlorhexidine β-CD-MSN Composites as Wound Dressing. Int J Nanomed. 2023; 2023(18):1725-1740.
[8] WANG Z, LI J, QIAO Y, et al. Rapid Ferroelectric-Photoexcited Bacteria-Killing of Bi4Ti3O12/Ti3C2Tx Nanofiber Membranes. Adv Fiber Mater. 2023;5(2):484-496.
[9] RANJBARI S, DARROUDI M, HATAMLUYI B, et al. Application of MXene in the diagnosis and treatment of breast cancer: A critical overview. Front Bioeng Biotech. 2022;10(984336):1-15.
[10] ZHENG S, ZHAO W, CHEN J, et al. 2D Materials Boost Advanced Zn Anodes: Principles, Advances, and Challenges. Nanomicro Lett. 2023;15(46):1-22.
[11] ELKHOURY K, RUSSELL C, SANCHEZ-GONZALEZ L, et al. Soft-Nanoparticle Functionalized Natural Hydrogels for Tissue Engineering Applications. Adv Healthcare Mater. 2019;8(18):e1900506.
[12] ZHANG YZ, LEE KH, ANJUM DH, et al. MXenes stretch hydrogel sensor performance to new limits. Sci Adv. 2018;4(6):eaat0098.
[13] HASSAN S, CECEN B, PEÑA-GARCIA R, et al. Survival and Proliferation under Severely Hypoxic Microenvironments Using Cell-Laden Oxygenating Hydrogels. J Funct Biomater. 2021;12(2):30.
[14] THI PL, LEE Y, TRAN DL, et al. Calcium peroxide-mediated in situ formation of multifunctional hydrogels with enhanced mesenchymal stem cell behaviors and antibacterial properties. J Mater Chem B. 2020;8(48):11033-11043.
[15] ZHANG X, WEI P, YANG Z, et al. Current Progress and Outlook of Nano-Based Hydrogel Dressings for Wound Healing. Pharmaceutics. 2022;15(1):68.
[16] 王赛楠,王晓菲,张莉.甲基丙烯酰明胶水凝胶作为细胞三维培养支架在骨组织工程中的应用[J].中国组织工程研究,2024, 28(22):3576-3582.
[17] ZHOU B, JIANG X, ZHOU X, et al. GelMA-based bioactive hydrogel scaffolds with multiple bone defect repair functions: therapeutic strategies and recent advances. Biomater Res. 2023;27(1):86-134.
[18] HU B, QIAO W, CAO Y, et al. A sono-responsive antibacterial nanosystem co-loaded with metformin and bone morphogenetic protein-2 for mitigation of inflammation and bone loss in experimental peri-implantitis. Front Bioeng Biotech. 2024;12:1410230.
[19] WANG Y, WEI Q. Editorial on the Special Issue “Modification of Hydrogels and Their Applications in Biomedical Engineering”. Gels. 2023;9(4):263.
[20] ZHOU T, YU Y, HE B, et al. Ultra-compact MXene fibers by continuous and controllable synergy of interfacial interactions and thermal drawing-induced stresses. Nat Commun. 2022;13(4564):1-13.
[21] XIE Y, CHENG Y, MA Y, et al. 3D MXene‐Based Flexible Network for High‐Performance Pressure Sensor with a Wide Temperature Range. Adv Sci. 2022;10(6):2205303.
[22] CUI D, KONG N, DING L, et al. Ultrathin 2D Titanium Carbide MXene (Ti3C2Tx) Nanoflakes Activate WNT/HIF-1𝜶-Mediated Metabolism Reprogramming for Periodontal Regeneration. Adv Healthcare Mater. 2021;10(22):2101215.
[23] KUMAR S, KANG D, HONG H, et al. Effect of Ti3C2Tx MXenes etched at elevated temperatures using concentrated acid on binder-free supercapacitors. RSC Adv. 2020;10(68):41837-41845.
[24] LI F, CHOONG TSY, ABDULLAH LC, et al. Effective Removal of Glyphosate from Aqueous Systems Using Synthesized PEG-Coated Calcium Peroxide Nanoparticles: Kinetics Study, H2O2 Release Performance and Degradation Pathways. Polymers. 2023;15(3):775.
[25] LI X, CHEN S, LI J, et al. 3D Culture of Chondrocytes in Gelatin Hydrogels with Different Stiffness. Polymers. 2016;8(8):269.
[26] NIE R, SUN Y, LV H, et al. 3D printing of MXene composite hydrogel scaffolds for photothermal antibacterial activity and bone regeneration in infected bone defect models. Nanoscale. 2022;14(22):8112-8129.
[27] ZHAO Y, WANG X, QI R, et al. Recent Advances of Natural-Polymer-Based Hydrogels for Wound Antibacterial Therapeutics. Polymers. 2023;15(15):3305.
[28] HAN M, SUN W, CHEN Y, et al. Fabrication of a photothermal antibacterial platform for bacterial infectious skin wound healing: a review. Mol Syst Des Eng. 2024;9(8):800-813.
[29] NAGHAVI M, MURRAY CJL, IKUTA KS, et al. Global burden of antimicrobial resistance: essential pieces of a global puzzle - Authors’ reply. Lancet. 2022;399(10344):2349-2350.
[30] BERNARDES BG, DEL GAUDIO P, ALVES P, et al. Bioaerogels: Promising Nanostructured Materials in Fluid Management, Healing and Regeneration of Wounds. Molecules. 2021;26(13):3834.
[31] HAN Z, DENG L, CHEN S, et al. Zn2+-Loaded adhesive bacterial cellulose hydrogel with angiogenic and antibacterial abilities for accelerating wound healing. Burns Trauma. 2023;11: tkac048.
[32] ZOGHI S. Advancements in Tissue Engineering: A Review of Bioprinting Techniques, Scaffolds, and Bioinks. Biomed Eng Comput Biol. 2024;15: 11795972241288099.
[33] ZHANG W, DU A, LIU S, et al. Research progress in decellularized extracellular matrix-derived hydrogels. Regen Ther. 2021;18:88-96.
[34] YOU S, XIANG Y, QI X, et al. Harnessing a biopolymer hydrogel reinforced by copper/tannic acid nanosheets for treating bacteria-infected diabetic wounds. Mater Today Adv. 2022;15:100271.
[35] SHIEKH PA, SINGH A, KUMAR A. Data supporting exosome laden oxygen releasing antioxidant and antibacterial cryogel wound dressing OxOBand alleviate diabetic and infectious wound healing. Data Brief. 2020;31:105671.
[36] YIN L, LI Y, YAO X, et al. MXenes for Solar Cells. Nano-Micro Lett. 2021;13:78.
[37] YE S, ZHANG H, LAI H, et al. MXene: A wonderful nanomaterial in antibacterial. Front Bioeng Biotech. 2024;12:1338539.
[38] LIU N, YU L, LIU B, et al. Ti3C2-MXene Partially Derived Hierarchical 1D/2D TiO2/Ti3C2 Heterostructure Electrode for High-Performance Capacitive Deionization. Adv Sci. 2022;10(2):2204041.
[39] YAN S, LI L, ZHANG H, et al. Flexible Sandwich-Shaped Cellulose Nanocrystals/Silver Nanowires/MXene Films Exhibit Efficient Electromagnetic-Shielding Interference Performance. Nanomaterials. 2024;14(7):647.
[40] RASOOL K, HELAL M, ALI A, et al. Antibacterial Activity of Ti3C2Tx MXene. ACS Nano. 2016;10(3):3674-3684.
[41] ARABI SHAMSABADI A, SHARIFIAN GH M, ANASORI B, et al. Antimicrobial Mode-of-Action of Colloidal Ti3C2Tx MXene Nanosheets. ACS Sustain Chem Eng. 2018;6(12):16586-16596.
[42] ZHANG W, ZHANG C, YANG C, et al. Photochemically-driven highly efficient intracellular delivery and light/hypoxia programmable triggered cancer photo-chemotherapy. J Nanobiotechnol. 2023; 21:11.
[43] 罗浙,练雷栋,干开丰.释氧生物材料用于组织工程的研究进展[J].南京医科大学学报(自然科学版),2024,44(9):1292-1297.
[44] TEH SW, KOH AEH, TONG JB, et al. Hypoxia in Bone and Oxygen Releasing Biomaterials in Fracture Treatments Using Mesenchymal Stem Cell Therapy: A Review. Front Cell Dev Biol. 2021; 9:634131.
[45] SHASHA Z, CHUANCHUAN H, YAWEN Z. The Progress and Prospect of calcium peroxide nanoparticles in antibacterial activity. Colloid Interface Sci Commun. 2024;61:100793.
[46] 路冬冬,朱天峰,张一健,等.3D生物打印甲基丙烯酰化明胶水凝胶支架促进软骨下骨缺损的修复[J].中国组织工程研究,2022, 26(34):5454-5460.
[47] QI ML, LI M, YUAN K, et al. Fabrication and X-ray microtomography of sandwich-structured PEEK implants for skull defect repair. Sci Rep. 2024;14:28585.
[48] LIANG C, WANG H, LIN Z, et al. Augmented wound healing potential of photosensitive GelMA hydrogel incorporating antimicrobial peptides and MXene nanoparticles. Front Bioeng Biotech. 2023;11:1310349.
[49] XIONG S, ZHANG Y, ZENG J, et al. DLP fabrication of HA scaffold with customized porous structures to regulate immune microenvironment and macrophage polarization for enhancing bone regeneration. Mater Today Bio. 2023;24:100929.
[50] GU H, LI H, WEI L, et al. Collagen-based injectable and self-healing hydrogel with multifunction for regenerative repairment of infected wounds. Regen Biomater. 2023;10:rbad018.
[51] SEIDI F, ARABI SHAMSABADI A, DADASHI FIROUZJAEI M, et al. MXenes Antibacterial Properties and Applications: A Review and Perspective. Small. 2023;19(14):2206716.
[52] XU S, CHANG L, HU Y, et al. Tea polyphenol modified, photothermal responsive and ROS generative black phosphorus quantum dots as nanoplatforms for promoting MRSA infected wounds healing in diabetic rats. J Nanobiotechnol. 2021;19:362.
[53] ZHAO H, WANG T, FANG X, et al. 2D MXene Nanosheets with ROS Scavenging Ability Effectively Delay Osteoarthritis Progression. Nanomaterials (Basel). 2024;14(19):1572.
[54] LI J, MA J, FENG Q, et al. Building Osteogenic Microenvironments with a Double-Network Composite Hydrogel for Bone Repair. Research(Wash D C). 2023;6:0021.
[55] YANG M, CAI X, WANG C, et al. Highly Stable Amorphous (Pyro)phosphate Aggregates: Pyrophosphate as a Carrier for Bioactive Ions and Drugs in Bone Repair Applications. ACS Omega. 2024;9(22): 23724-23740.
[56] MUBARAKI S, PANI SC, ALSERAIHY A, et al. The efficacy of two different oral hygiene regimens on the incidence and severity of oral mucositis in pediatric patients receiving hematopoietic stem cell transplantation: A prospective interventional study. Spec Care Dentist. 2020;40(6): 566-573.
|